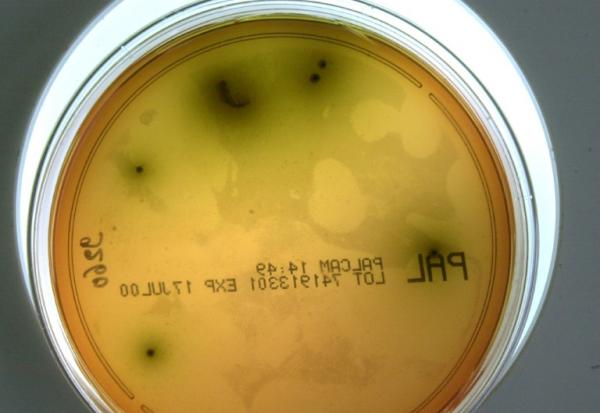
Gros plan d'une souche de listeria pris le 10 mai 2000 au laboratoire d'analyse départementale de la Manche à St Lo

Etats-Unis : le "dividende Trump" devra être approuvé par le Congrès
Raisonnable, le "chèque" de 2.000$ ?

Le secrétaire américain au Trésor, Scott Bessent, a déclaré que la proposition de Donald Trump d'accorder aux citoyens américains des "dividendes" de 2.000 dollars provenant des droits de douane nécessiterait l'approbation du Congrès. "On verra", a déclaré Bessent dimanche sur Fox News, ajoutant qu'il faudra "une loi pour cela". Trump, qui avait vanté les milliards de dollars de recettes douanières américaines engrangées cette année, a évoqué récemment ces chèques potentiels alors que la frustration grandit au sein de la population américaine face au coût de la vie, rappelle Bloomberg. S'adressant aux journalistes à bord d'Air Force One vendredi, Trump a déclaré que les chèques seraient envoyés l'année prochaine à "tous sauf aux riches". Le président américain a indiqué qu'il s'agissait d'une "somme considérable", mais que les droits de douane avaient rapporté beaucoup. "Nous allons également réduire la dette", a assuré Trump.
Selon une estimation relayée par Bloomberg, ce plan de "dividendes" pourrait coûter au gouvernement américain le double des recettes prévues d'ici 2025. Le Comité pour un budget fédéral responsable, un organisme de surveillance centriste cité par l'agence, a estimé le coût préliminaire de cette proposition à 600 milliards de dollars, si les dividendes étaient conçus sur le modèle des aides publiques versées pendant la pandémie de Covid-19. Les recettes douanières nettes américaines pour l'exercice fiscal clos en septembre se sont élevées à 195 milliards de dollars, et de nombreux économistes prévoient environ 300 milliards de dollars pour l'année civile 2025.
Bessent a déclaré que les Américains devraient commencer à ressentir un soulagement économique plus marqué dès le début de l'année prochaine, citant les réductions d'impôts prévues par la réforme phare de Trump, adoptée plus tôt cette année. Il s'attend ainsi à ce que, durant les deux premiers trimestres, la courbe d'inflation s'infléchisse et que la courbe des revenus réels s'accélère sensiblement...
Les informations et conseils rédigés par la rédaction de Boursier.com sont réalisés à partir des meilleures sources, même si la société Boursier.com ne peut en garantir l'exhaustivité ni la fiabilité. Ces contenus n'ont aucune valeur contractuelle et ne constituent en aucun cas une offre de vente ou une sollicitation d'achat de valeurs mobilières ou d'instruments financiers. La responsabilité de la société Boursier.com et/ou de ses dirigeants et salariés ne saurait être engagée en cas d'erreur, d'omission ou d'investissement inopportun.
- 0 vote
- 0 vote
- 0 vote
- 0 vote
- 0 vote